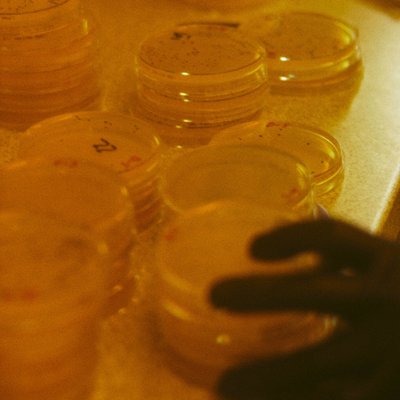

|
What's happening
US news ⋅ Yesterday
NYT op-ed argues news outlets should stop airing Trump's coronavirus briefings
New York Times columnist Charles Blow makes a case against carrying President Trump's briefings live, arguing that "a...
US news ⋅ 21 minutes ago
Tom Brady asked to leave Tampa park after he was spotted working out
Tampa Mayor Jane Castor said that Brady was sighted working out by himself at a park downtown by staff patrol. The st...
Businessweek ⋅ Yesterday
Regeneron's coronavirus treatment could be saving lives by fall
Antibody treatments may be the best hope against coronavirus until a vaccine. Regeneron's drug cocktail could be test...
Businessweek ⋅ Yesterday
There's one big reason why oil crashed on Monday: inelasticity
The historic crash in oil prices on Monday—to below zero, believe it or not—can be explained with one wonky word: "in...
ET Canada ⋅ 2 hours ago
Melissa McCarthy Surprises Her Deserving Aunt & Uncle
Melissa McCarthy is left in tears as she surprises Aunt & Uncle with stunning home renovation on "Celebrity IOU"
World news ⋅ Yesterday
Israeli political rivals form unity government to end more than a year of deadlock
Prime Minister Benjamin Netanyahu and opponent Benny Gantz reached an agreement on Monday, which will see Netanyahu c...
We sent this email to @Veersydarfer. Unsubscribe
Twitter, Inc. 1355 Market Street, Suite 900 San Francisco, CA 94103

No comments:
Post a Comment